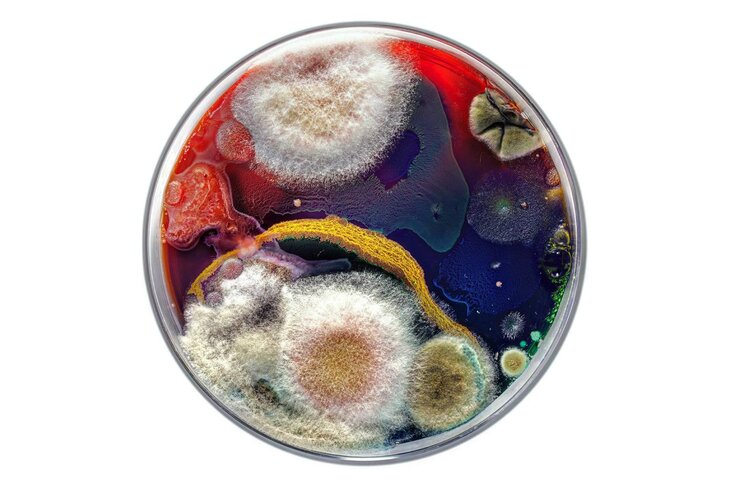

Дарю картины. Современное искусство
13:59
Выбросил №216 - ссылка на видео
Моего друга ваш акционизм укрепил во мнении, что он создает вечное, пока понятное только ему одному из всего населения Земли. Но скоро...
Это вы про "иконописца"?
Где же вы раньше были :) Примерно год назад я собрал всё масло и акрил, попредлагал знакомым, даже на авито выставлял. Опять никому не надо было. Так и выкинул полпакета этого "добра"
Сейчас я краски сам готовлю по своей рецептуре из натуральных ингридиетнов. Храняться всего, примерно, 3 дня. Так, что не вариант.
Могу, если хотите, пигмента железноокисного отсыпать - черного и терракотового - грамм по двести. у меня его довольно много.
14:01
№217. Темпера. Холст на осб. 63х63см.
Отсутствующий рефлекс Маршрута. Это когда человек не может грамотно построить маршрут. Про таких говорят - "заблудится в трех соснах".
[
Ну да.
15:26
Моего друга ваш акционизм укрепил во мнении, что он создает вечное, пока понятное только ему одному из всего населения Земли. Но скоро...
Я рад, что его что то укрепило, но откровенно говоря ко мне иногда приходят с "...понятным только ему одному из всего населения Земли...", а потом оказывается, что его в детстве по голове треугольным предметом огрели...
Ну, примерно то же и он сказал о том, кто выбрасывает.
Отсутствующий рефлекс Маршрута. Это когда человек не может грамотно построить маршрут. Про таких говорят - "заблудится в трех соснах".
Смотря какие вызовы были у человека. Ваша работа - устаревшая морально. Плохая. Даже топографический кретинизм - не оправдание для затраты краски и времени. Попробуйте то же самое в синергии. :) Уверена: либо маршрут, либо рефлекс, - определятся в интригующий результат. А так - да. Несите на помоечку. Вы уже лет 100 как задолжали ей.
Случай, когда путь до помойки оказался дольше, чем до галереи при отсутствии рефлекса Маршрута.
Яёи Кусама – женщина, которая больше 40 лет добровольно живет в психиатрической клинике и продает свои картины по несколько миллионов долларов. Раз в день Кусама покидает стены психиатрички, чтобы заниматься картинами. Самый дорогой художник современности. Работы украшают лучшие выставки мира. На персональные выставки художницы билеты продают на определенное время, чтобы исключить столпотворение.
"В конце все утилизирую: ко мне приезжает специальная компания и сжигает чаши. Это считается отходами класса В."
Биохудожница Даша Плесень делает арт-объекты с плесенью.
Выдающийся биохудожник Билибин почти в каждой своей работе изображал грибы. Но псевдоним Ваня Гриб взять не догадался. 
Есть существенная разница. Билибин грибы в соавторы не брал. :)
Поправлюсь.
Яёи Кусама в отличие от нашего героя, проложила маршрут к помойке через ПНД (дурку) и заработала мильёны. Соответственно, рефлекс Маршрута у неё присутствует. Какие выводы напрашиваются?
Это как посмотреть. Ведь известно из мемуаров и даже рисунков пристрастие большого мастера к грибам и водке, что вызывало изменение сознания. А если это не соавторство, то можно с уверенностью сказать что грибы и алокоголь его музы.
Борис Кустодиев. Портрет Ивана Билибина (фрагмент). 1914
12:36
Краткое резюме темы: Художница Даша Плесень делает картины за $5 000 000 не выходя из психбольницы.
А я думала, что мы о новаторстве Кусамских способов впасть в транс, используя графические паттерны, не прибегая к рюмке и грибам. :) О том, что маршрут будем пролагать так, чтобы наверняка заблудиться даже в двух соснах. :)
Ложное направление. Петер Коглер.
"Чистое искусство" без влияния плесени кишечника, глистов, церебрального атеросклероза, грибов и алкоголя возможно в исполнении ИИ второго и третьего поколения, когда воздействие человеческого разума на творческий процесс машины будет сведено к нулю.
Ну-ну... Не горячитесь, Алексей. Мы сегодня так хорошо сопровождаем нашего мальчика на помойку, раскрываем аспекты, заложенные в его работе... При этом акцентируем внимание на том, что это было не чуждо другим исполнителям.
Но римовингом они не занялись, в отличие от нашего мальчика... Утрачивать и стирать объект, как приём. Может, посмотрим, как он работает? Если уж с "паттернами" маршрутизации более-менее маякнули. :)
Я же не отговариваю от творчества, при этом понимая, что смысл существования хомо - заполнение канализации и помоек!
Би - вы тоже играете? Ваш проложенный маршрут указывает на понимание темы. :)
И кладбищ.



Живопись
Графика
Батик
Авторская кукла
Ювелирное искусство
Скульптура
Икона
Вышитые картины
Стекло, витражи
Роспись стен
Мозаика
Декоративное искусство
Аэрография
Жикле, принты, постеры
















